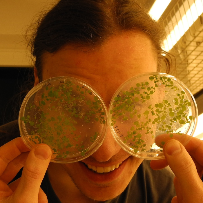
Profile picture

Tomáš HLUSKA
Doctorate
-
Post Doctoral ResearcherInstitute of Experimental Botany, Academy of Sciences of the Czech RepublicPrague, Czechia
